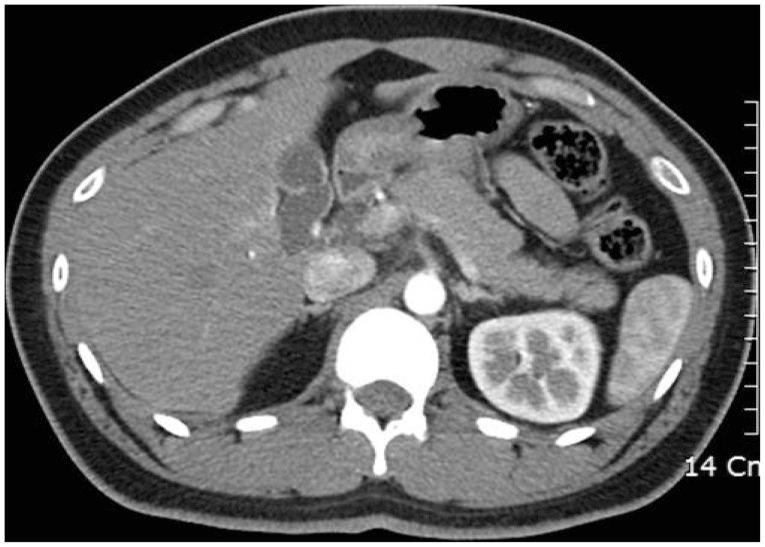

十二指肠溃疡引起的急性胰腺炎。
Acute pancreatitis due to a duodenal ulcer.
作者信息
Pyeon Sung Ik, Hwang Jong Ho, Kim Yong Tae, Lee Ban Seok, Lee Sang Ho, Lee Jae Nam, Cheong Jae Hoon, Oh Kong Jin
机构信息
Department of Internal Medicine, Busan Medical Center, Busan, Korea.
Department of Internal Medicine, Seoul National University Hospital, Seoul National University College of Medicine, Seoul, Korea.
出版信息
Clin Endosc. 2014 Nov;47(6):579-83. doi: 10.5946/ce.2014.47.6.579. Epub 2014 Nov 30.
Duodenal ulcers and acute pancreatitis are two of the most commonly encountered gastrointestinal diseases among the general population. However, duodenal ulcer-induced pancreatitis is very rarely reported worldwide. This report elaborates on a distinct medical treatment that contributes to partial or complete treatment of acute pancreatitis induced by a duodenal ulcer scar.
十二指肠溃疡和急性胰腺炎是普通人群中最常见的两种胃肠道疾病。然而,十二指肠溃疡诱发的胰腺炎在全球范围内鲜有报道。本报告详细阐述了一种独特的医学治疗方法,该方法有助于部分或完全治愈由十二指肠溃疡瘢痕诱发的急性胰腺炎。